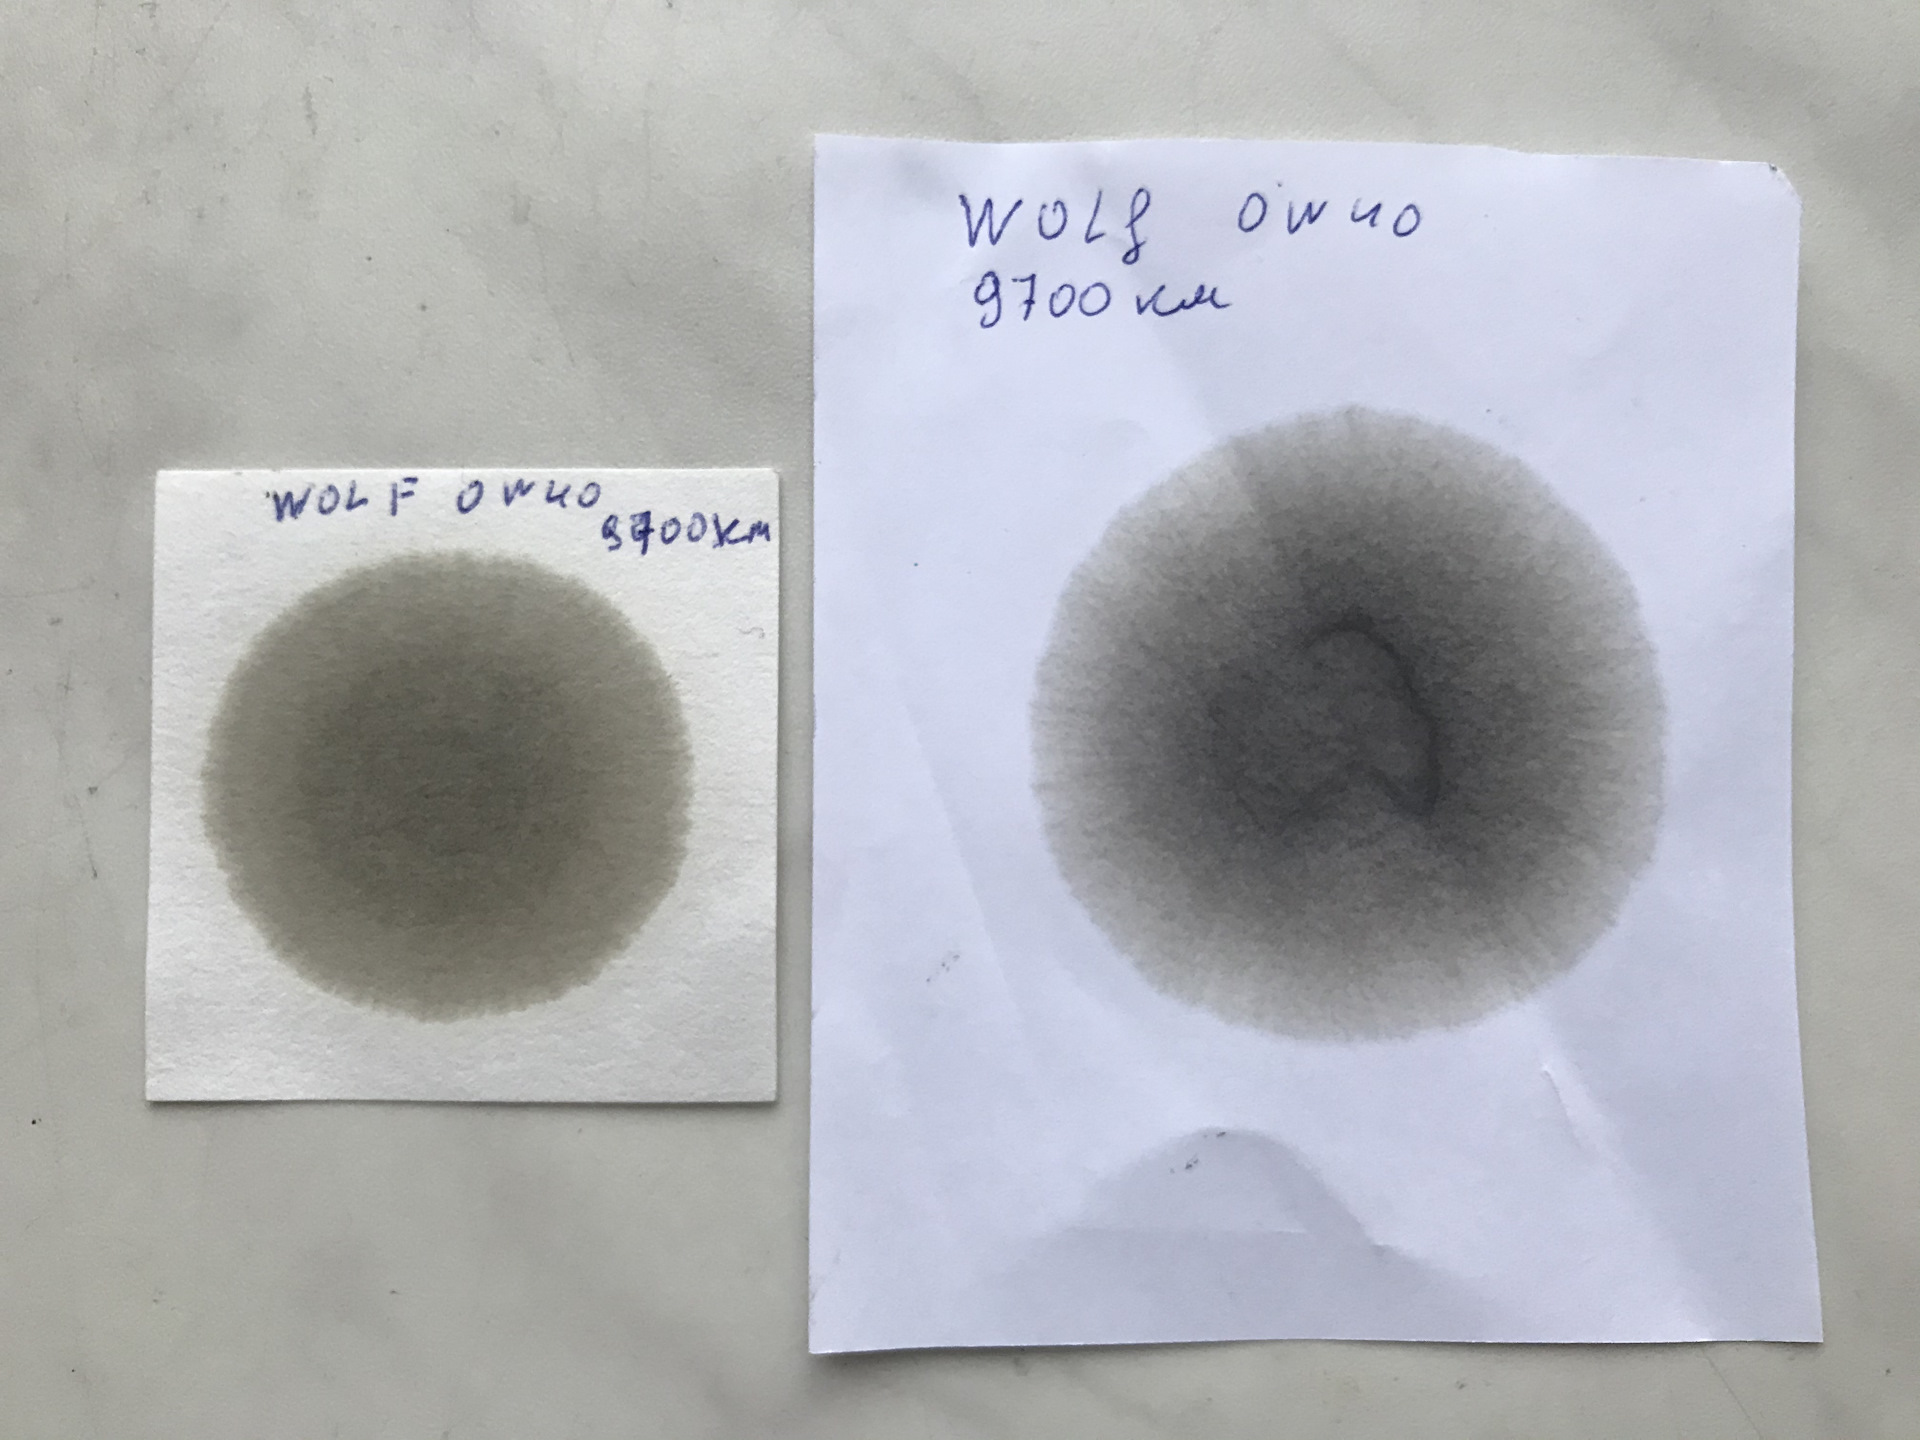
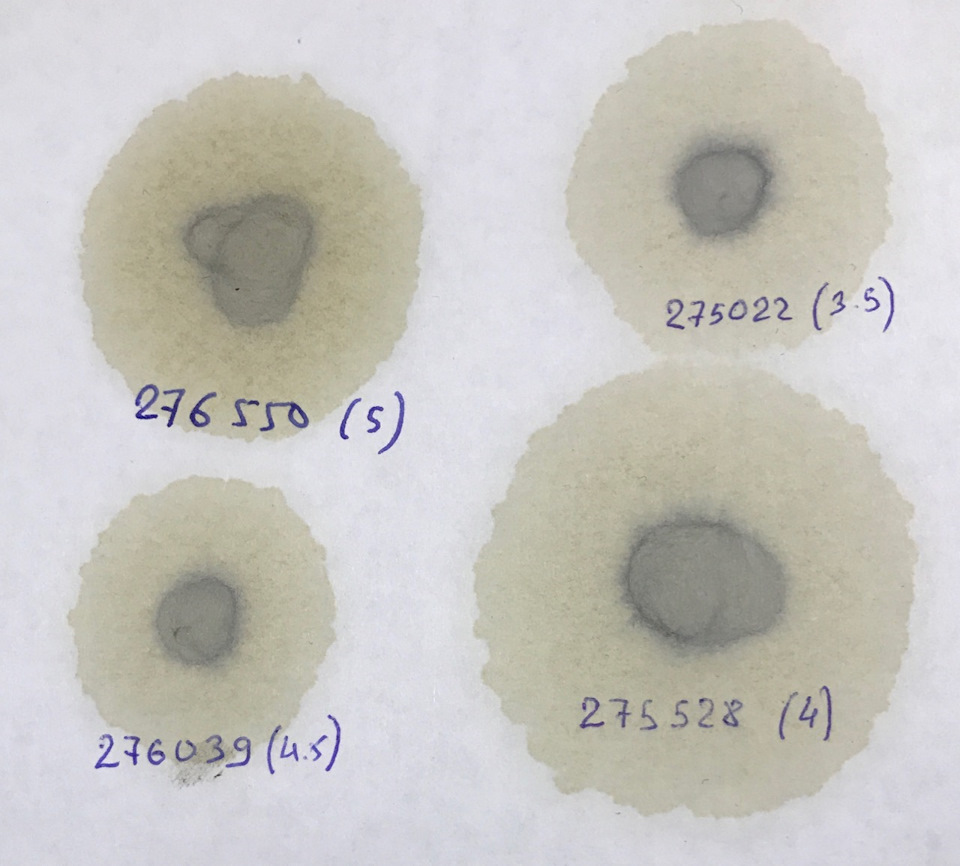

Тест масла вмп
Люминесцентная краска это
Пол лицо все к лицу
Ну что еще хочешь сказать
210073618 вб видео
Gl novels
Когда начинаются выборы в 2025
Дрожжевого теста утопленник
Выплаты на детей с низким
Не готовы тратить время
18 old lady
Баратынский шуми шуми
Греческие боги хаос
Ремофлекс эвалар показания отзывы
Тест масла вмп 106 фото